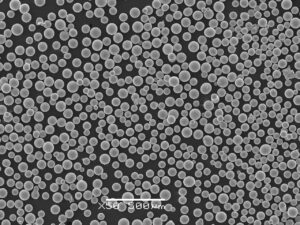
HAZIRLIK 5 Nikel Bazlı Tozlar

Plazma Dönen Elektrot Prosesi (PREP)
Shanghai Truer Industrial Development Co, Ltd
Plazma Döner Elektrot Proses Tozları:
Plazma Dönen Elektrot Prosesi (PREP) nedir?
Plazma Dönen Elektrot Prosesi (PREP), elektrik iletken malzemeler için küresel tozlar üretmek için mükemmel bir yöntem olarak kabul edilir. ve prensibi ve ayrıntılı süreçleri gibidir:
Yüksek hızda dönen elektrot (hammadde), yüksek saflıkta inert atmosferin koruması altında plazma arkı tarafından eritilir ve erimiş metal, inert atmosfer tarafından atomize edilmek üzere büyük merkezkaç kuvveti ile dışarı atılır ve soğuk odanın iç duvarına temas ettiğinde küresel tozlar halinde yoğunlaşır.
Plazma Döner Elektrot Prosesi Toz özellikleri:
1) Düşük oksijen ve diğer safsızlık artışı (yüksek saflık)
2) Mükemmel küresel ve esasen uydusuz
3) Dar partikül boyutu dağılımı, yüksek akışkanlık ve yüksek görünür/paketleme yoğunluğu
4) Düşük iç gözeneklilik
Böylece HAZIRLANMIŞ metalik tozlar SEBM, SLM, DED, Bağlayıcı püskürtme, Lazer kaplama, PM vb. için uygulanabilir.
Plazma Döner Elektrot Prosesinin Avantajları:
Plazma döner elektrot süreci (PREP sistemi) metal tozları ve kaplamaların üretimi için çeşitli avantajlar sunar. Temel avantajlardan bazıları şunlardır:
Yüksek kaliteli, küresel metal tozları: Proses, düzgün boyut dağılımına ve yüksek küreselliğe sahip ince, küresel metal tozları üretir. Bu özellikler, tutarlı toz özelliklerinin optimum performans için çok önemli olduğu eklemeli üretim gibi çeşitli uygulamalarda arzu edilir.
Geniş malzeme ve alaşım yelpazesi: PREA/REP, refrakter metaller, yüksek sıcaklık malzemeleri ve gelişmiş alaşımlar dahil olmak üzere çok çeşitli metalleri ve alaşımları işleyebilir. Bu çok yönlülük, onu farklı malzeme gereksinimleri olan birçok endüstri için uygun hale getirir.
Kontrollü partikül boyutu ve dağılımı: Elektrot dönüş hızı, plazma gazı akış hızı ve güç girişi gibi proses parametreleri, üretilen metal tozlarının partikül boyutunu ve dağılımını kontrol etmek için ayarlanabilir. Bu esneklik, belirli uygulamalar için özel özelliklere sahip tozların üretilmesine olanak tanır.
Düşük kirlenme seviyeleri: Prosesin temassız doğası nedeniyle, çevredeki ortamdan veya diğer kaynaklardan kirlenme riski minimumdur. Bu da havacılık ve tıbbi cihazlar gibi katı saflık gereksinimleri olan uygulamalar için uygun yüksek saflıkta metal tozları elde edilmesini sağlar.
Özelleştirilebilir proses parametreleri: Plazma döner elektrot prosesi, proses parametreleri ayarlanarak özel uygulama gereksinimlerini karşılayacak şekilde uyarlanabilir. Bu uyarlanabilirlik, partikül boyutu, morfoloji ve kimyasal bileşim gibi özel özelliklere sahip metal tozlarının üretilmesine olanak tanır.
Yüksek üretim oranları: Gaz atomizasyonu gibi diğer toz üretim yöntemleriyle karşılaştırıldığında PREA/REP, sürekli yapısı ve elektrot malzemesinin tozlara verimli bir şekilde dönüştürülmesi nedeniyle daha yüksek üretim hızlarına ulaşabilir.
Verimli malzeme kullanımı: Proses, elektrot malzemesini ince tozlara dönüştürmede etkilidir, bu da diğer toz üretim yöntemlerine kıyasla minimum atık ve daha yüksek malzeme kullanımı ile sonuçlanır.
Bu avantajlar, plazma döner elektrot prosesini havacılık, otomotiv, tıbbi cihazlar ve elektronik gibi endüstrilerdeki çeşitli uygulamalar için yüksek kaliteli metal tozları üretmek için değerli bir teknik haline getirmektedir.
Plazma Döner Elektrot Proses Uygulamaları:
Dikkat çeken uygulamalardan bazıları şunlardır:
Havacılık ve uzay endüstrisi: a. Yüksek performanslı alaşımların üretimi: PREA/REP, uçaklar, uzay araçları ve motorlar için yüksek mukavemetli, hafif ve korozyona dayanıklı bileşenlerin üretiminde kullanılan gelişmiş metal tozları üretebilir. b. Termal bariyer kaplamaları: Proses, türbin kanatları ve diğer motor bileşenleri için termal bariyer kaplamaları oluşturmak için kullanılabilir, bu da yüksek sıcaklıklı ortamlarda performanslarını ve dayanıklılıklarını artırır.
Otomotiv endüstrisi: a. Hafif bileşenlerin üretimi: PREA/REP ile üretilen metal tozları, araçlar için hafif ve yüksek mukavemetli bileşenler oluşturmak için kullanılabilir, bu da yakıt verimliliğine ve emisyonların azaltılmasına katkıda bulunur. b. Aşınmaya dayanıklı kaplamalar: Proses, motor bileşenleri ve yüksek aşınmaya maruz kalan diğer otomotiv parçaları için aşınmaya dayanıklı kaplamalar üretmek ve hizmet ömürlerini uzatmak için kullanılabilir.
Tıbbi cihazlar: a. Biyouyumlu malzemelerin üretimi: PREA/REP kullanılarak üretilen yüksek kaliteli metal tozları, ortopedik ve diş implantları gibi biyouyumlu malzemelerin ve implantların üretiminde kullanılabilir. b. İlaç dağıtım sistemleri: Proses, tıbbi tedavilerin etkinliğini artıran kontrollü ilaç salım sistemleri için özel metal tozları oluşturmak için kullanılabilir.
Elektronik: a. İletken malzemelerin üretimi: PREA/REP ile üretilen metal tozları, baskılı devre kartları, konektörler ve sensörler gibi elektronik bileşenler için iletken malzemeler oluşturmak için kullanılabilir. b. Manyetik malzemeler: Süreç, veri depolama cihazları, motorlar ve transformatörler dahil olmak üzere çeşitli elektronik uygulamalar için manyetik malzemeler üretmek için kullanılabilir.
Enerji sektörü: a. Yakıt hücresi bileşenleri: PREA/REP, katalizörler ve elektrotlar gibi yakıt hücresi bileşenlerinin imalatı için metal tozları üretmek üzere kullanılabilir ve yakıt hücrelerinin performansını ve verimliliğini artırır. b. Güneş enerjisi uygulamaları: Proses, fotovoltaik hücreler ve termal enerji depolama sistemleri gibi güneş enerjisi uygulamaları için metal tozları üretebilir.
Katmanlı üretim: a. 3D baskı için metal tozları üretimi: PREA/REP tarafından üretilen yüksek kaliteli, küresel metal tozları, seçici lazer sinterleme (SLS) ve elektron ışını eritme (EBM) gibi eklemeli üretim süreçleri için idealdir ve çeşitli sektörlerde karmaşık ve özelleştirilmiş bileşenlerin oluşturulmasını sağlar.
Bu uygulamalar, çok çeşitli endüstriler ve amaçlar için yüksek kaliteli metal tozları ve kaplamalar üretmede plazma döner elektrot işleminin çok yönlülüğünü ve değerini göstermektedir.
3D Baskı
Makine Endüstrisi
Metalurji Endüstrisi
Medikal Endüstrisi
Plazma Döner Elektrot Proses Ekipmanları:
Plazma döner elektrot prosesi (PREP sistemi), yüksek kaliteli metal tozları ve kaplamalar üretmek için özel ekipman gerektirir. Kurulumun temel bileşenleri şunları içerir:
Plazma torcu: Plazma torcu, dönen elektrottan metalin eritilmesinde ve atomize edilmesinde hayati bir rol oynayan yüksek hızlı bir plazma jeti üretir. PREA/REP'te kullanılan yaygın plazma torcu türleri, dönen elektrotla doğrudan temas etmeden torcun elektrodu ile nozul arasında bir elektrik arkını koruyan aktarmasız ark torçlarıdır.
Güç kaynağı: Plazmanın üretilmesi ve sürdürülmesi için plazma torcuna gerekli elektrik enerjisini sağlamak üzere bir güç kaynağı gereklidir. Güç kaynağı, işlenmekte olan belirli malzeme için gerekli voltaj ve akım seviyelerini sağlayabilmelidir.
Dönen elektrot: Dönen elektrot, toz veya kaplama haline getirilecek metal veya alaşımdan yapılır. Motor tahrikli bir mil üzerine monte edilir ve tipik olarak birkaç bin RPM aralığında yüksek hızlarda döndürülür. Elektrot döndükçe, plazma jeti yüzeyine çarparak malzemeyi eritir ve atomize eder.
Motor ve iş mili sistemi: Motor ve iş mili sistemi, elektrotun dönüşünü sağlamaktan sorumludur. Sistem, belirli malzeme ve proses parametreleri için gerekli dönme hızı ve torku sağlayabilmelidir. Ayrıca, işlem sırasında oluşan ısıyı yönetmek için bir soğutma mekanizması da içerebilir.
Gaz beslemesi: Plazma gazı beslemesi, plazma jetinin üretilmesi ve sürdürülmesi için gereklidir. Argon, helyum veya nitrojen gibi inert gazlar proseste yaygın olarak kullanılır. Gaz besleme sistemi, belirli plazma torcu ve işlenen malzeme için gerekli gaz akış hızını ve basıncını sağlayabilmelidir.
Toplama sistemi: Üretilen metal tozlarını veya kaplamaları yakalamak için bir toplama sistemi kullanılır. Bu, tozları proses gazlarından ayırmak için bir toz toplama odası veya bir filtre sistemi içerebilir. Toplama sisteminin tasarımı, istenen toz özelliklerine ve partikül boyutu dağılımına bağlı olarak değişebilir.
Kontrol sistemi: Bir kontrol sistemi, plazma torç gücü, elektrot dönüş hızı ve gaz akış hızı gibi çeşitli proses parametrelerinin yönetilmesi ve izlenmesinden sorumludur. Kontrol sistemi, süreci düzenlemek ve yüksek kaliteli metal tozlarının veya kaplamaların tutarlı bir şekilde üretilmesini sağlamak için sensörler, aktüatörler ve programlanabilir bir mantık denetleyicisi (PLC) veya bilgisayar tabanlı bir sistem içerebilir.
Bu temel bileşenler, plazma döner elektrot sürecini kolaylaştırmak için birlikte çalışarak farklı endüstrilerdeki çeşitli uygulamalar için yüksek kaliteli metal tozları ve kaplamaların üretilmesini sağlar.
SLPA-N
Orta ölçekli PREP sistemi (SLPA-N), aşağıdaki özelliklere sahip yüksek kaliteli küresel metal tozlarının sürekli, endüstriyel seri üretimi için özel olarak tasarlanmıştır:
- Orta ölçekli üretim için makul maliyet
- Ergonomi dostu, kullanımı kolay
- Basit ve profesyonel insan-makine arayüz tasarımı
- Nispeten yüksek ince toz çıkış hızı (ortalama dönüş hızı: 30.000 rpm)
- Üretilen tozlar yüksek küreselliğe ('ın üzerinde) ve inert koruma atmosferinde atomize edilmesi nedeniyle düşük gözenekli tozlar, düşük uydu tozları, yüksek saflık (düşük oksijen artışı, ≤120ppm) gibi yüksek kaliteye sahiptir.
- Erime sıcaklığı ≥2600 ℃, Ti-alaşımları, Çelikler, Süperalaşımların üretimi için uygundur,
- Refrakter alaşımlar, yüksek entropili alaşımlar, vb.
SLPA-D
Küçük ölçekli PREP sistemi (SLPA-D, masaüstü seviyesi), yeni alaşım tozlarının Ar-Ge'si ve aşağıdaki özelliklere sahip yüksek kaliteli tozların küçük seri üretimi için özel olarak tasarlanmıştır:
- Çoklu küçük parti üretimi için nispeten daha düşük maliyet
- Çoklu küçük parti ve çeşitlendirilmiş toz üretimi için daha hızlı geçiş (zaman azaltma)
- Ergonomi dostu, kullanımı kolay
- Basit ve profesyonel insan-makine arayüz tasarımı
- Yüksek dönme hızı (50.000 rpm'ye kadar) sayesinde yüksek ince toz çıkış oranı
- Üretilen tozlar yüksek küreselliğe ('in üzerinde) ve inert koruma atmosferinde atomize edilmesi nedeniyle düşük gözenekli tozlar, düşük uydu tozları, yüksek saflık (düşük oksijen artışı, ≤100ppm) gibi yüksek kaliteye sahiptir.
- Çubukları elektro-iletken olan neredeyse tüm metal tozlarını, özellikle refrakter metaller, yüksek aktiviteli metaller, süper alaşımlar vb. için üretebilir.
SLPA-H
Büyük ölçekli PREP ekipmanı (SLPA-H), aşağıdaki özelliklere sahip yüksek kaliteli küresel metal tozlarının sürekli, endüstriyel seri üretimi için özel olarak tasarlanmıştır:
- Büyük seri üretim için makul maliyet
- Ergonomi dostu, kullanımı kolay
- Basit ve profesyonel insan-makine arayüz tasarımı
- Nispeten daha düşük ince toz çıkış oranı (20.000 rpm'ye kadar dönüş hızı)
- Üretilen tozlar yüksek küreselliğe ('ın üzerinde) ve inert koruma atmosferinde atomize edilmesi nedeniyle düşük gözenekli tozlar, düşük uydu tozları, yüksek saflık (düşük oksijen artışı, ≤200ppm) gibi yüksek kaliteye sahiptir.
- Erime noktası ≤2.600 ℃ olan metal tozlarının üretimi için uygundur
hakkimizda
Gerçek Endüstri
Shanghai Truer Industrial Development Co, Ltd 2009 yılında kurulmuş ve 2019 yılında, eklemeli üretimin mühendislik uygulamalarına yardımcı olmak için entegre 3D baskı tozu yapım ekipmanı ve hizmetleri, yüksek kaliteli 3D baskı tozları oluşturmaya adanmış eklemeli üretim işini yaratmıştır.
Şirket sadece profesyonel seçici elektron ışını eritme (SEBM) teknolojisi ve ekipmanı sağlamakla kalmaz, aynı zamanda plazma döner elektrot işlemi toz yapma (PREP) teknolojisi ve ekipmanı da sağlar. Ayrıca TiNi, TiTa, TiAl, TiNbZr, CoCrMo ve benzeri dahil olmak üzere çeşitli derecelerde küresel metal tozlarına sahibiz.
Bize Mesaj Gönderin
Bize ulaşın
satış
Cassiel Ding
+86 – 13611869448
[email protected]
Satış Müdürü
Lucy Wen
+86 - 15250232891
[email protected]
Kalite Kontrol
Mike Wu
+86 – 13862291355
[email protected]
satış
Joan Zhou
+86 – 17316565943
[email protected]
Müşteri Hizmetleri
Luke Zhang
+86 – 15250014048
[email protected]